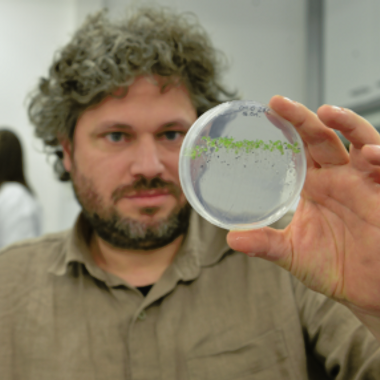
Prof Marcel Quint

Plant
The Session information is still subject to change.
P2 - International Plant Systems Biology
Session Description
Systems biology enables interactions between plant components to be characterised, often using predictive modelling and large-scale omics datasets. In recent years, the acceleration of Next Generation Sequencing techniques and the development of single cell analyses and other methods have increased the complexity of information that biologists can generate. On the other hand, the emergence of AI technologies broaden the research questions that can be tackled by providing new means for data integration and mining. This workshop will unite researchers across career stages and across these diverse areas of study who are keen to share insights in order to drive new understanding of plant biology.
This session is proudly sponsored by the Journal of Experimental Botany, The Plant Journal and Fundación Instituto de Biología Integrativa
P3 - Talking about Resilience: Volatile Organic Compounds in Plant Communication
Session Description
Plants produce thousands of volatile organic compounds (VOCs) used in their communication within and amongst individuals in interactions with animals (pollinators, frugivores, and pests), pathogens and beneficial microorganisms. VOC profiles are modulated by circadian rhythms, development and stress responses. We will cover plant VOC biosynthesis, release and perception resulting in communication, with an emphasis on communication resulting in increased stress resilience. As well as fundamental studies on plant biochemistry and signalling we will include applications of VOCs in priming for stress tolerance and as markers in development, and in post-harvest biology to assess changes in metabolism.
Proudly sponsored by
P4 - Plant Epigenetics Across The Scales: Development and Plasticity
Session Description
In eukaryotic organisms, somatic cells share the same primary DNA sequence, yet form a diversity of tissues and functions within complex multicellular organs. A major driver of this diversity is chromatin, a complex structure of DNA and histone proteins that regulates the spatio-temporal expression of transcriptional networks. This session will bring together scientists investigating the role of chromatin dynamics and epigenetics in shaping plant development and stress adaptation, with an emphasis on molecular and genomic approaches. The session aims to showcase the most recent advances in plant epigenetics, highlighting the epigenome as a target for improving crop resilience and key to our understanding of plant development and adaptation.
Poudly sponsored by
P5 - Insights into Multi-Scale Plant Environmental Physiology: PEPG at 50
Session Description
This session marks the 50th anniversary of the establishment of the Plant Environmental Physiology Group (PEPG) at the SEB. This session wants to highlight new insights into the physiological drivers of plant resilience to abiotic stress. The session will showcase work on below and aboveground process and at different organisatonal scales (from molecular to ecosystem), but with a focus on how these processes and scales can be integrated in innovative ways. We view this integration as essential to improving resilience to climate change. The overarching aim is to update our theoretical understanding, methodologies or modelling approaches to plant environmental physiology.
Sponsored by the Journal of Experimental Botany
P6 - Harnessing Plant Associated Microbial Communities for Plant Stress Resilience
Session Description
Plant-associated microbial communities are integral to plant development, nutrition, and health. As climate change increases drought, nutrient limitation, and disease pressure, research is shifting from descriptive microbiome surveys to mechanistic and translational insights into how microbial communities support their hosts. This session will highlight advances in understanding beneficial interactions - from rhizosphere communities to endophytes and holobiont networks - and how they can be harnessed to improve plant stress resilience. We will examine microbial traits, plant genetic determinants, and ecological and environmental drivers that shape outcomes, and discuss strategies for community engineering, predictive ecology, and robust standards for testing inoculants and synthetic communities across lab-to-field scales.
P7 - siRNAs and Long Noncoding RNAs in Plant and Animal Development
Session Description
This session will focus on the role of noncoding RNAs in developmental processes. We will consider a broad variety of plant and animal models and put a special focus on siRNAs and long noncoding RNAs, two molecule types that are only beginning to emerge as important players in developmental biology.
P8 - Epigenetic Tools: From Observation to Causality
Session Description
Recent years have seen a surge in publications suggesting an important role of epigenetic mechanisms in plant tolerance and resistance to biotic and abiotic stresses. However, moving from correlation to causation remains a major challenge in this field. While powerful molecular tools to manipulate epigenetic marks at defined genomic loci are emerging (e.g. SunTag-based systems), their adoption and optimisation in plant systems remains limited. This session will bring together leading experts to showcase current technologies, discuss practical and conceptual challenges, and engage the community in an open exchange of ideas. The discussion will inform a shared roadmap for advancing epigenetic toolkits in plant biology and catalyse future collaborative funding to develop new crop protection biotechnology.
P11 - Complexity in Plant Genomes: From Making to Expression
Session Description
This session explores how plant genomes are organized, maintained, and expressed in both nuclear and organellar systems across diverse green lineages. It highlights advances in high-resolution functional genomics and genome engineering, and will cover all aspects from pre- to post-transcriptional regulation that ensure proper genome expression. By uniting molecular biologists, genome engineers, computational scientists, and biotechnologists, the session encourages interdisciplinary exchange and provides a platform to discuss emerging tools and conceptual advances in genome biology. It aims to deepen understanding of genome maintenance and expression processes and to connect fundamental discoveries with practical applications. The session will highlight how cutting-edge genomic research can drive crop improvement and sustainable agriculture.
This session is sponsored by Journal Experimental Botany
P12 - Plant Robustness from Molecules to Ecosystems
Session Description
This session will focus on the remarkable ability of plants to withstand stress without perturbing their growth, a trait known as robustness. Organismal robustness can be achieved by either resistance, where organisms remain unchanged upon stress, or resilience, where they recover from stress by either returning to the original state or shifting to a new state. Even though plant stress responses have been studied for decades, what makes plants robust to individual or multiple stresses is still an unresolved question. What are the mechanisms underlying plant robustness, and how does that operate on different scales between cells, tissues and ecosystems? Are plant robustness mechanisms conserved across land plants? Can we engineer robustness to environmental perturbations in crops? These questions will be discussed in individual oral presentations by invited speakers, supported by short talks from ECRs selected from abstracts. The session will conclude with a fishbowl discussion to synthesize the conceptual advances and novel strategies for investigating plant robustness.
The session is sponsored by The Plant Journal